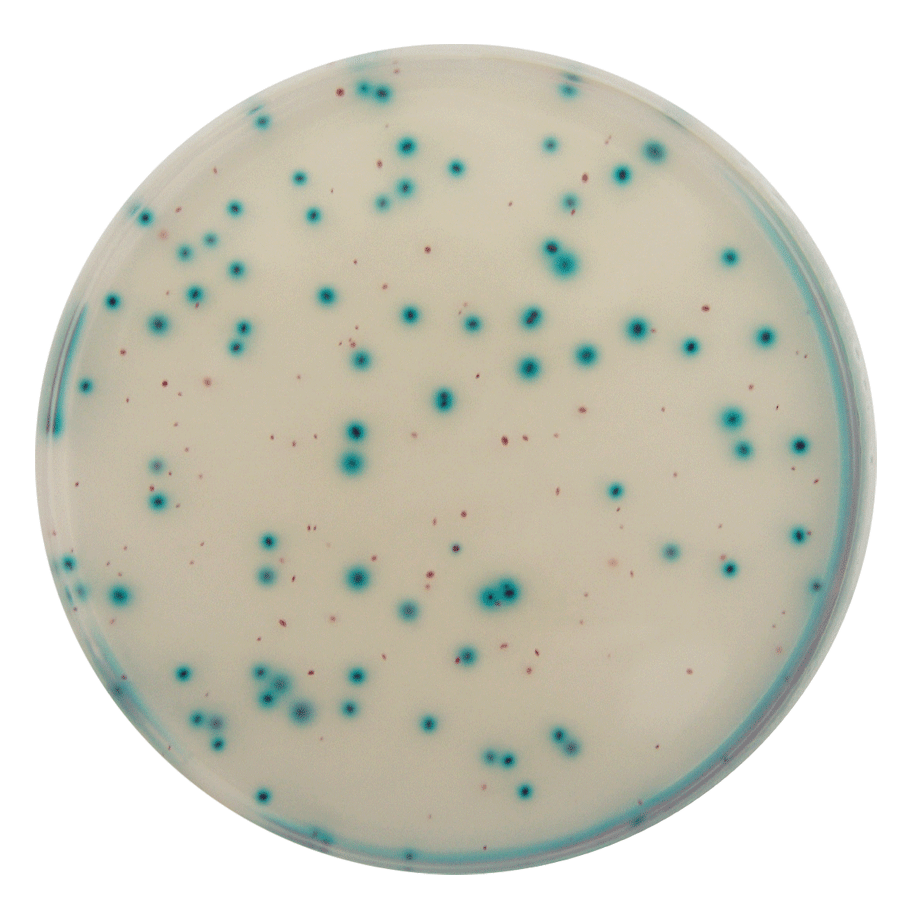

Depuis sa création, notre laboratoire « LAB2A-SARL » s’engage chaque jour à garantir la fiabilité, la rigueur et la qualité scientifique de ses analyses. Dans un monde en constante évolution, où les exigences en matière de sécurité alimentaire, de traçabilité et de performance environnementale se renforcent chaque jour, le rôle du laboratoire « LAB2A » est d’offrir des solutions fiables et adaptées aux besoins de ses partenaires.
Grâce aux essais inter-laboratoires, aux audits internes, à des équipements de pointe et à une équipe d’experts passionnés, nous garantissons des résultats fiables, un accompagnement technique personnalisé et une approche centrée sur la confiance et la transparence.
Notre laboratoire ne cesse d’augmenter le champ de ses accréditations afin de couvrir un nombre toujours plus large de paramètres analytiques et ainsi répondre aux besoins de ses partenaires. Par ses engagements, notre laboratoire affirme sa volonté de contribuer activement à la protection du consommateur et à la compétitivité durable du secteur de l’agro-industrie.
- Contact@lab2a.ma
- Av. Al Haour, Rabat 10100, Maroc
- Devis en ligne
Laboratoire accrédité
Au service de l’Agriculture et de l’Agroalimentaire.


Un laboratoire accrédité
Résultats précis, fiables, certifiés.
Laboratoire multisectoriel au service de l’agriculture
Lab2A est un laboratoire d’analyses agricoles et agroalimentaires, créé dans l’optique de participer à l’essor de l’agriculture et de l’industrie agroalimentaire


Expertise scientifique, confiance durable.
Votre devis en ligne en 30 secondes
Obtenez votre devis personnalisé en seulement 30 secondes ! Rapide, simple et gratuit, notre service en ligne vous permet d’estimer vos besoins sans attendre.


Laboratoire accrédité et Agréé

Mot du directeur
Recherche Scientifique

&
Démarche Qualité
Laboratoire LAB2A
Lab2A est une équipe pluridisciplinaire, composée principalement d’ingénieurs pédologues, d’agronomes, de biologistes, de chimistes, de qualiticiens, de techniciens spécialisés de laboratoire et de chargés d’études. Notre équipe est à votre disposition pour commenter ensemble l’interprétation de vos résultats, n’hésitez pas à nous contacter pour obtenir des compléments d’information.
- Lab2A est doté d’équipements performants de dernière génération (ICP AES, UPLC-MSMS, GC-MSMS, Thermocycleurs,…), spécialement conçus pour optimiser le circuit analytique et répondre efficacement l’ensemble de nos engagements.
140+
Paramètres accrédités
10k+
Analyses réalisées
Nos domaines d'expertise
Laboratoire d’analyses agricoles et agroalimentaires
Votre Laboratoire de Confiance pour des Analyses Fiables et Accréditées
Clients accompagnés
Analyses réalisées
Taux de satisfaction
Domaines d’expertise
Nos Valeurs
-
Authenticité
Méthodes les plus appropriées aux essais
-
Fiabilité
La fiabilité des résultats est au centre de nos activités
-
Régularité
Meilleur délai des résultats en utilisant la technologie de pointe
-
Intégrité
Respect de l’éthique et de l’impartialité


Avis
Témoignages de Nos Partenaires
Nous collaborons avec ce laboratoire depuis plusieurs années pour nos contrôles qualité. Le service est rapide, précis et toujours conforme aux normes internationales. Une équipe professionnelle sur laquelle nous pouvons compter au quotidien.

Carrefour Maroc
Le laboratoire nous accompagne dans nos projets de recherche et nos travaux académiques. Les analyses sont fiables, les délais respectés et l’équipe est extrêmement compétente. Une véritable référence scientifique

UIR
Grâce aux analyses agronomiques et conseils du laboratoire, nous avons nettement amélioré la productivité et la santé de nos cultures. Un partenaire sérieux, réactif et indispensable à notre activité.

Aïn Ifrane, Exploitation Agricole
Team Member
Focusing Your Mind, with The
Best Expert.
Nos partenaires
Ils Travaillent Avec Nous














Contact
Notre équipe est là pour vous aider.
Retrouvez-Nous Facilement
Recent Article
Interesting Articles Updated
Every Daily
Une question sur nos analyses ? Écrivez-nous sur WhatsApp